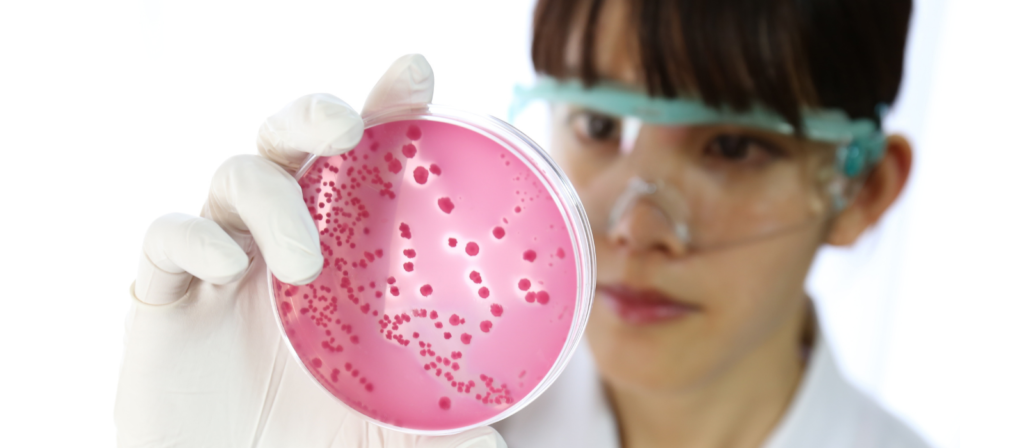

O que é Ágar Cled?
O meio de cultura Cystine-Lactose-Electrolyte-Deficiente mais conhecido como Ágar Cled é descrito pela primeira vez por Sandys e posteriormente modificado por Mackey e Sandys, é geralmente usado para bacteriologia urinária de rotina diagnóstica como um meio de cultura não seletivo capaz de suportar o crescimento da maioria dos patógenos urinários.
Qual a função do Ágar Cled?
O Ágar Cled é um meio de cultura diferencial utilizado para o isolamento e enumeração de bactérias da urina. O meio suporta o crescimento de todos os patógenos potenciais urinários e fornece morfologia de colônia distinta. Apoia o crescimento de patógenos e contaminantes urinários e dá uma boa diferenciação colonial sem a disseminação de espécies de Proteus devido à sua falta de eletrólitos.
Composição do Ágar Cled
| Constituintes | g/litro |
| Lactose | 10,0 |
| Digestão Enzimática de Gelatina | 4,0 |
| Digestão Enzimática de Caseína | 4,0 |
| Extrato de carne bovina | 3,0 |
| L-cistina | 0,128 |
| Azul de Bromotimol | 0,02 |
| Ágar | 15,0 |
Príncípio do Ágar Cled
O Ágar CLED é composto por digestão enzimática de caseína, uma digestão enzimática de gelatina e extrato de carne bovina que fornecem nitrogênio, vitaminas, minerais e aminoácidos essenciais para o crescimento. A L-cistina suporta o crescimento da colônia de coliformes anões dependentes de cisteína.
A lactose é um carboidrato fermentável que fornece carbono e energia. Organismos capazes de fermentar a lactose irão baixar o pH e mudar a cor do meio de verde para amarelo.
A mudança de cor é indicada pela presença do indicador de pH Bromthymol Blue. O ágar presente no meio é o agente solidificante.
Preparação do Ágar Cled
- Suspenda 36 gramas do meio em um litro de água destilada.
- Misture bem e aqueça com agitação frequente e ferva por um minuto até completar a dissolução.
- Autoclave a 121°C por 15 minutos.
- Arrefecer a 50°C, misturar bem e distribuir em pratos. Quando o meio estiver solidificado, inverta as placas para evitar excesso de umidade. O meio preparado deve ser armazenado a 8-15°C.
Usos do Ágar Cled
- O Ágar Cled ´e usado para cultura de urina de rotina e usos para crescimento e enumeração de organismos do trato urinário.
- Ajuda na diferenciação de fermentador de lactose e não fermentador de lactose.
- É adequado para o isolamento e contagem de muitos microrganismos de crescimento aeróbico, como Enterobacteriaceae, Pseudomonas e outros bastonetes Gram negativos não fermentadores, enterococos, estafilococos, espécies de Candida e muitos outros de amostras de urina.
Limitações do Ágar Cled
- Estreptococos e outros organismos que necessitam de sangue ou soro para crescimento podem ser recuperados apenas de forma insuficiente neste meio ou podem necessitar de incubação prolongada. Portanto, a amostra também deve ser cultivada em uma placa de ágar sangue se tais organismos forem esperados.
- Patógenos geniturinários como Neisseria gonorrhoeae , Gardnerella vaginalis , Chlamydia , Ureaplasma ou outros organismos exigentes não crescem neste meio.
- Testes sorológicos usando culturas puras são necessários para a identificação completa.
Perguntas Frequentes sobre o Ágar Cled
P : Por que o ágar CLED é deficiente em eletrólitos?
R : O ágar CLED é deficiente em eletrólitos para evitar a enxameação excessiva de espécies de Proteus . Crisley mostrou que uma cepa de Proteus vulgaris cultivada na presença de cloreto de sódio utilizou mais glicose e cresceu em maior extensão do que quando cultivada na ausência de cloreto de sódio. Naylor mostrou que esse aumento de crescimento, na presença de NaCl, é um fator que causa o enxame de Proteus.
P : Ágar Cled é seletivo?
R : O ágar CLED é um meio não seletivo , permite o crescimento de uma ampla variedade de germes não exigentes
P : A Salmonella cresce no CLED?
R : Sim, a salmonela pode crescer no CLED , a salmonela não utiliza lactose (colônias azul-esverdeadas na superfície do ágar CLED).
P : Por que a E coli cresce como colônias amarelas no ágar CLED?
R : Organismos capazes de fermentar lactose, como a E coli, baixam o pH e mudam a cor do meio para amarelo (as colônias ficam amareladas porque o ágar fica amarelado)
Precisa comprar meios de cultura? Consulte nossa equipe:
AVISO DE DIREITOS AUTORAIS: Todo o material deste blog, sendo proibida toda e qualquer forma de plágio, cópia, reprodução ou qualquer outra forma de uso.
Qualquer dúvida técnica sobre os equipamentos contidos no portfólio SPLABOR, entre em contato com o Departamento de Vendas (sp@splabor.com.br)

A Splabor é uma empresa líder no ramo de fabricação de equipamentos para laboratório, especializada em oferecer uma ampla variedade de equipamentos para laboratórios, materiais e produtos para laboratório de alta qualidade.